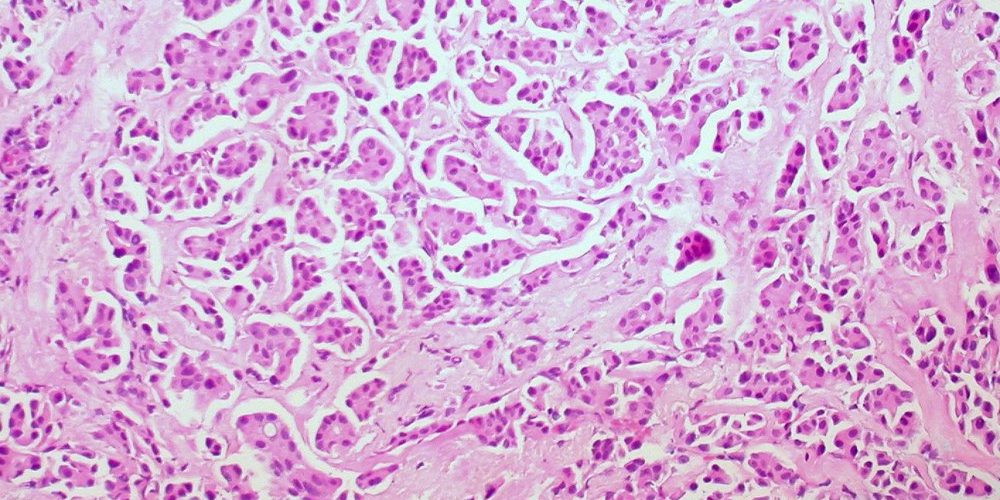
Андрогены могут помочь в лечении рака груди

Андрогены могут помочь в лечении рака груди

Исследователи из Университета Аделаиды нашли новые доказательства положительной роли андрогенов в лечении рака груди с немедленными последствиями для женщин с метастатическим заболеванием эстроген-положительного типа.
Международное исследование, опубликованное в журнале Nature Medicine, рассматривало роль андрогенов, обычно считающихся мужскими половыми гормонами, но также обнаруживаемых в более низких концентрациях у женщин, в качестве потенциального лечения эстроген-положительного рака груди.
Используя модели клеточной линии и полученные от пациентов, команда ученых, продемонстрировала, что активация рецептора андрогена природным андрогеном или новым андрогенным препаратом обладает мощной противоопухолевой активностью во всех опухолях с эстроген-положительным типом рака, даже в устойчивых к действующим вариантам лечения. При этом ингибиторы рецепторов андрогенов не действовали.
«Эта работа имеет непосредственное значение для женщин с метастатическим раком молочной железы эстроген-положительного типа, в том числе для женщин, устойчивых к современным формам эндокринной терапии», — комментирует Тереза Хики, доцент Университета Аделаиды, одна из авторов исследования.
${number_format( Math.floor(Math.random()*1000000+300000), 0, ‘.’, ‘ ‘ )}
${number_format( Math.floor(Math.random()*100+21), 0, ‘.’, ‘ ‘ )}
`
preElement.appendChild( meta )
return block;
}
var content = document.querySelector( ‘.xfolkentryDesc’ ),
prePs = [].slice.call( content.children ),
elementPS = [],
ps = []
for( p in prePs ) {
ps.push( prePs[p] )
let brs = prePs[p].querySelectorAll( ‘br’ )
ps.push( …brs )
// console.log( ‘brs’, brs )
}
// console.log( ‘ps’, ps );
if( ps.length = window.innerHeight * 0.05) && (elemRect.top
материал med2.ru